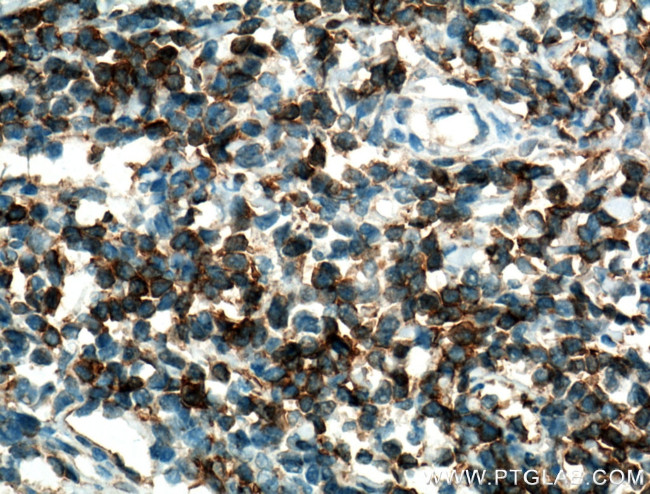
CD28 Antibody in Immunohistochemistry (Paraffin) (IHC (P))

Search
Proteintech
CD28 Polyclonal Antibody
{{$productOrderCtrl.translations['antibody.pdp.commerceCard.promotion.promotions']}}
{{$productOrderCtrl.translations['antibody.pdp.commerceCard.promotion.viewpromo']}}
{{$productOrderCtrl.translations['antibody.pdp.commerceCard.promotion.promocode']}}: {{promo.promoCode}} {{promo.promoTitle}} {{promo.promoDescription}}. {{$productOrderCtrl.translations['antibody.pdp.commerceCard.promotion.learnmore']}}
产品信息
26174-1-AP
种属反应
宿主/亚型
分类
类型
抗原
偶联物
形式
浓度
纯化类型
保存液
内含物
保存条件
运输条件
产品详细信息
Immunogen sequence: RSKRSRLLHS DYMNMTPRRP GPTRKHYQPY APPRDFAAYR S
靶标信息
CD28 antigen is a 44 kDa disulfide linked homodimeric T cell specific surface glycoprotein. CD28 is a cell adhesion molecule of the immunoglobulin superfamily which is constitutively expressed on most peripheral blood T lymphocytes. Moreover, CD28 is the critical T cell costimulatory receptor that provides the cell the important second activation signal by binding CD80 and CD86 which are expressed by antigen presenting cells. In addition to its co-stimulation role, CD28 functions by preventing T cells from entering an anergic-hyporesponsive state or from undergoing premature apoptotic cell death. In murine peripheral lymphoid organs and in the blood, all CD4+ and CD8+ T cells express CD28. In the thymus, CD28 expression is highest on immature CD3-, CD8+ and CD4+8+ cells, and on CD4-8- cells that express alpha/beta and gamma/delta TCR. The level of CD28 on mature CD4+ and CD8+ alpha/beta TCR+ thymocytes is two- to fourfold lower than on the immature cells. Diseases associated with CD28 dysfunction include mycosis fungiodes and Sezary's Disease.
仅用于科研。不用于诊断过程。未经明确授权不得转售。
篇参考文献 (0)
生物信息学
蛋白别名: CD28; CD28 antigen; MGC138290; sCD28; soluble CD28; T-cell-specific surface glycoprotein CD28; T44; TP44
基因别名: CD28; Tp44
UniProt ID: (Human) P10747
Entrez Gene ID: (Human) 940